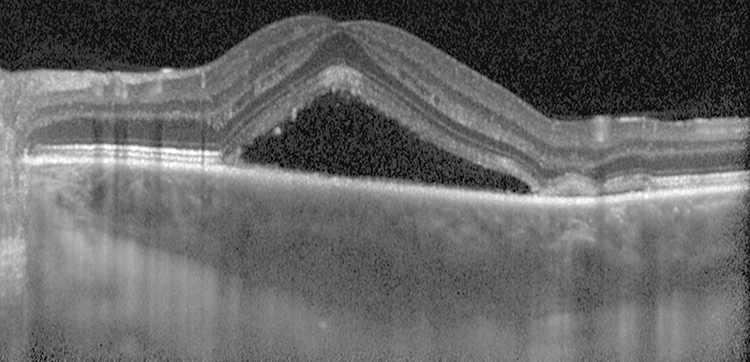
Rapuano9781975243722-ch011_f030.jpg

Central scotoma, blurred or dim vision, objects may appear distorted (metamorphopsia) and miniaturized (micropsia), colors may appear faded. Usually unilateral, but can be bilateral (more likely in older patients, may not be symptomatic at the same time). May be asymptomatic.
(See Figure 11.15.1.)
Figure 11.15.1: Central serous chorioretinopathy.

Critical
Localized serous detachment of the neurosensory retina in the macula without subretinal blood or lipid exudates. The margins of the detachment are sloping and merge gradually into the attached retina.
Other
Visual acuity usually ranges from 20/20 to 20/200. Amsler grid testing reveals relative scotoma and distortion of straight lines. May have a small serous RPE detachment or subretinal fibrin. Focal RPE changes may indicate sites of previous episodes. (Neither blood or lipid should be present. If so, CNV should be ruled out.)
These entities may produce a serous detachment of the neurosensory retina in the macula.
AMD: Patient usually ≥50 years old, drusen, pigment epithelial alterations, may have choroidal (subretinal) neovascularization, often bilateral. See 11.16, Nonexudative (Dry) Age-Related Macular Degeneration and 11.17, Neovascular or Exudative (Wet) Age-Related Macular Degeneration.
Optic pit: The optic disc has a small defect (a pit) in the nerve tissue. A serous RD may be present, contiguous with the optic disc. See 11.34, Optic Pit.
Macular detachment as a result of an RRD or macular hole: In RRD, a hole in the retina can be found. See 11.3, Retinal Detachment and 11.25, Vitreomacular Adhesion/Vitreomacular Traction/Macular Hole.
Choroidal tumor, particularly choroidal hemangioma: See 11.36, Choroidal Nevus and Malignant Melanoma of the Choroid.
HTN: See 11.10, Hypertensive Retinopathy.
Pigment epithelial detachment (PED): The margins of a PED are more distinct than those of CSCR, and the RPE is elevated. Occasionally, PED may accompany CSCR or AMD.
Others: Idiopathic choroidal effusion, inflammatory choroidal disorders, and chronic renal failure.